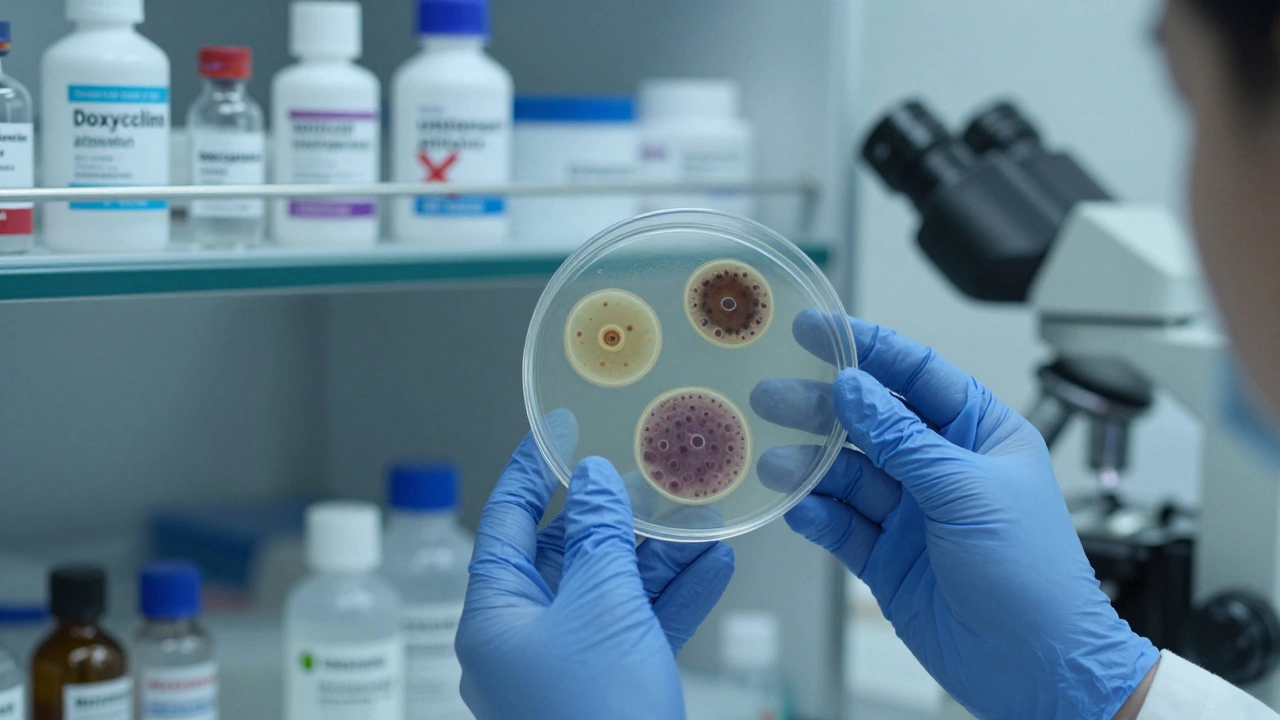
Lab technician examining bacterial colonies under a microscope with antibiotic vials in the background.

There’s no antibiotic that kills all bacteria-and that’s not a flaw. It’s biology.
Why no single antibiotic works on every bacteria
Bacteria aren’t all the same. They come in wildly different shapes, sizes, and survival strategies. Some have thick walls that block drugs. Others pump antibiotics out before they can do damage. Some even break them down like trash. That’s why a drug that wipes out one kind of infection might do nothing to another.Take Staphylococcus aureus, the bug behind many skin infections. It’s often killed by penicillin-like drugs. But Escherichia coli, a common gut bacterium, has natural defenses against those same drugs. And then there’s Enterococcus faecium, a hospital superbug that laughs at vancomycin-the last-resort antibiotic for resistant strains.
Antibiotics are like specialized keys. One key opens one lock. If the lock’s design changes-say, through mutation or gene swapping-the key stops working. That’s why doctors don’t hand out one-size-fits-all antibiotics. They test the infection first.
What about broad-spectrum antibiotics?
You’ve probably heard of drugs like doxycycline, ciprofloxacin, or meropenem. These are called broad-spectrum antibiotics because they hit a wider range of bacteria than narrow ones like penicillin. But even these don’t kill everything.Here’s what they can do:
- Target both Gram-positive and Gram-negative bacteria
- Work against common pathogens like H. pylori, Klebsiella, and some strains of Pseudomonas
- Be used in emergencies when the bug isn’t yet identified
But here’s what they can’t do:
- Kill anaerobic bacteria like Clostridioides difficile without triggering deadly side effects
- Touch spore-forming bacteria like Bacillus anthracis unless given at very high doses
- Eliminate antibiotic-resistant strains like MRSA or VRE
Even the strongest broad-spectrum drugs leave gaps. And using them unnecessarily? That’s how superbugs rise.
The myth of the universal antibiotic
You might think: if we just built a stronger drug, couldn’t we wipe out every bacterium? The answer is no-and here’s why.Antibiotics work by targeting specific parts of bacterial cells: their cell walls, protein factories, or DNA replication systems. But humans share similar biology. A drug that destroys a bacterial cell wall might also wreck your gut lining. A drug that shuts down bacterial protein production could poison your liver.
That’s why scientists can’t just design a universal killer. It would kill you before it killed the infection.
Even in extreme cases-like sepsis or meningitis-doctors don’t use one magic bullet. They use combinations. For example, a patient with hospital-acquired pneumonia might get meropenem + vancomycin + aztreonam all at once, hoping one of them sticks.
What happens when you try to use antibiotics too broadly?
Every time you take an antibiotic, especially when you don’t need it, you’re playing Russian roulette with your microbiome.Here’s what usually happens:
- You take amoxicillin for a sinus infection that’s actually viral
- The drug kills off the harmless bacteria in your gut
- The tough, resistant ones survive
- They multiply and spread
- Next time you’re sick, the same drug doesn’t work
This isn’t theory. A 2024 study from the Australian Institute of Health and Welfare showed that 37% of community-acquired urinary tract infections in Sydney were now resistant to amoxicillin-up from 12% in 2018. That’s not a glitch. It’s evolution.
And it’s not just about you. Resistant bacteria spread through hospitals, water systems, and even food. That’s why Australia’s National Antimicrobial Resistance Strategy now treats antibiotic misuse like a public health emergency.
What should you do instead?
If you’re sick and wondering if you need an antibiotic, here’s the real advice:- Most sore throats? Probably viral. No antibiotic needed.
- Most coughs and colds? Viral. Antibiotics won’t help.
- Yellow or green mucus? Doesn’t mean bacterial. That’s just your immune system at work.
- High fever, pus, or symptoms lasting more than 10 days? Then see a doctor.
Online consultations now let you upload photos of rashes, share symptom timelines, and even send lab results. Many GPs in Australia now use AI-assisted tools to predict whether an infection is bacterial or viral-before they even prescribe.
When antibiotics are needed, doctors don’t guess. They order:
- Culture tests (swabs or urine samples)
- PCR tests to detect bacterial DNA
- Antibiotic sensitivity panels
Then they pick the narrowest, most targeted drug possible. That’s the gold standard.

Are there any antibiotics that come close to universal?
Not really. But some come closer than others.Colistin is one of the last-resort drugs used against multidrug-resistant Gram-negative infections. It’s toxic to kidneys, so it’s only used when everything else fails. And even then, some bacteria-like those with the MCR-1 gene-can resist it.
Tigecycline covers a wide range, including MRSA and some anaerobes. But it doesn’t work well in the bloodstream, so it’s useless for sepsis.
Cefiderocol, approved in 2020, is one of the newest. It sneaks into bacteria by hijacking their iron transport system. It works against many superbugs. But it’s useless against Enterococcus and some fungi. And it’s not available over the counter. It’s given in hospitals under strict control.
There’s no silver bullet. And there won’t be.
What’s the future?
Scientists are exploring alternatives:- Bacteriophages-viruses that target specific bacteria. Already used in Georgia and Poland for decades.
- Antimicrobial peptides-natural compounds from frogs and insects that disrupt bacterial membranes.
- CRISPR-based therapies-gene-editing tools that can be programmed to kill only resistant strains.
None of these are ready for mass use yet. But they’re the real hope-not another broad-spectrum drug.
The truth? We can’t out-engineer evolution. We have to work with it. That means using antibiotics like precision tools, not sledgehammers.
Is there a single antibiotic that kills every type of bacteria?
No. There is no antibiotic that kills every type of bacteria. Bacteria are too diverse in structure and resistance mechanisms. Even the broadest-spectrum drugs miss certain types, like spore-formers, anaerobes, and resistant strains. The goal of modern medicine isn’t to kill everything-it’s to kill the right bug with the least damage to your body.
Why do doctors sometimes prescribe broad-spectrum antibiotics if they don’t kill everything?
They’re used when the exact cause of infection isn’t known yet-like in severe sepsis or pneumonia in hospitalized patients. The goal is to cover the most likely culprits while waiting for lab results. Once the bacteria are identified, doctors switch to a narrower, more targeted drug to reduce resistance risk.
Can I buy a strong antibiotic online to treat any infection?
No, and you shouldn’t try. In Australia, all antibiotics require a prescription. Online pharmacies selling antibiotics without a prescription are illegal and dangerous. You might get the wrong drug, the wrong dose, or fake medication. Misuse leads to resistance, which can make future infections untreatable.
Do probiotics help after taking antibiotics?
Some studies suggest probiotics may reduce the risk of antibiotic-associated diarrhea, especially with Clostridioides difficile. But they don’t restore your full microbiome. The best approach is to eat fiber-rich foods, avoid sugar, and give your gut time to recover. Don’t rely on supplements to fix damage from unnecessary antibiotic use.
How do I know if my infection needs an antibiotic?
Most infections-like colds, flu, sore throats, and most sinus infections-are viral and don’t need antibiotics. Signs you might need one include: fever over 38.5°C lasting more than 3 days, pus, worsening symptoms after 10 days, or signs of spreading infection like red streaks on the skin. Always consult a doctor. Online consultations can help you get a proper diagnosis without unnecessary prescriptions.





